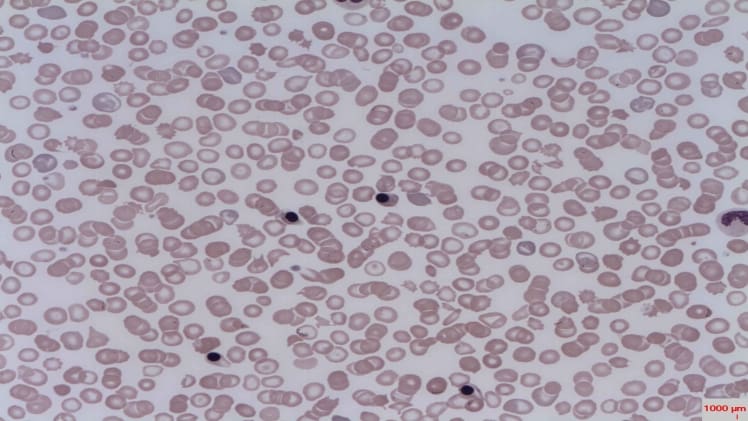

Nucleated red blood cells (NRBCs) are a type of red blood cell that contain a nucleus. They are often present in the bloodstream in newborns, but they tend to disappear over time. In some cases, however, they may persist into adulthood. In this article, we will explore what NRBCs are, their benefits, and why they may persist in some cases.
What are Nucleated Red Blood Cells?
Nucleated red blood cells are a type of red blood cell that have a nucleus, unlike most other red blood cells. They are typically larger than other red blood cells and can be identified by their distinctive shape. They are only present in the bloodstream for a short period of time in newborns, but can persist into adulthood in some cases.
Benefits of Nucleated Red Blood Cells
Nucleated red blood cells have several benefits.
Firstly, they are able to produce more hemoglobin than other red blood cells, which helps to increase the oxygen-carrying capacity of the blood. This helps to ensure that the body gets the oxygen it needs to function properly.
Secondly, they can also help to produce more white blood cells, which are important for fighting off infections. This helps to keep the body healthy and able to fight off any potential illnesses.
Finally, NRBCs can also help to clear away damaged red blood cells, which can help to keep the blood clean and healthy.
In conclusion, nucleated red blood cells are a type of red blood cell that contain a nucleus. They are typically only present in the bloodstream for a short period of time in newborns, but can persist into adulthood in some cases. They have several benefits, including increased hemoglobin production, increased white blood cell production, and the ability to clear away damaged red blood cells.